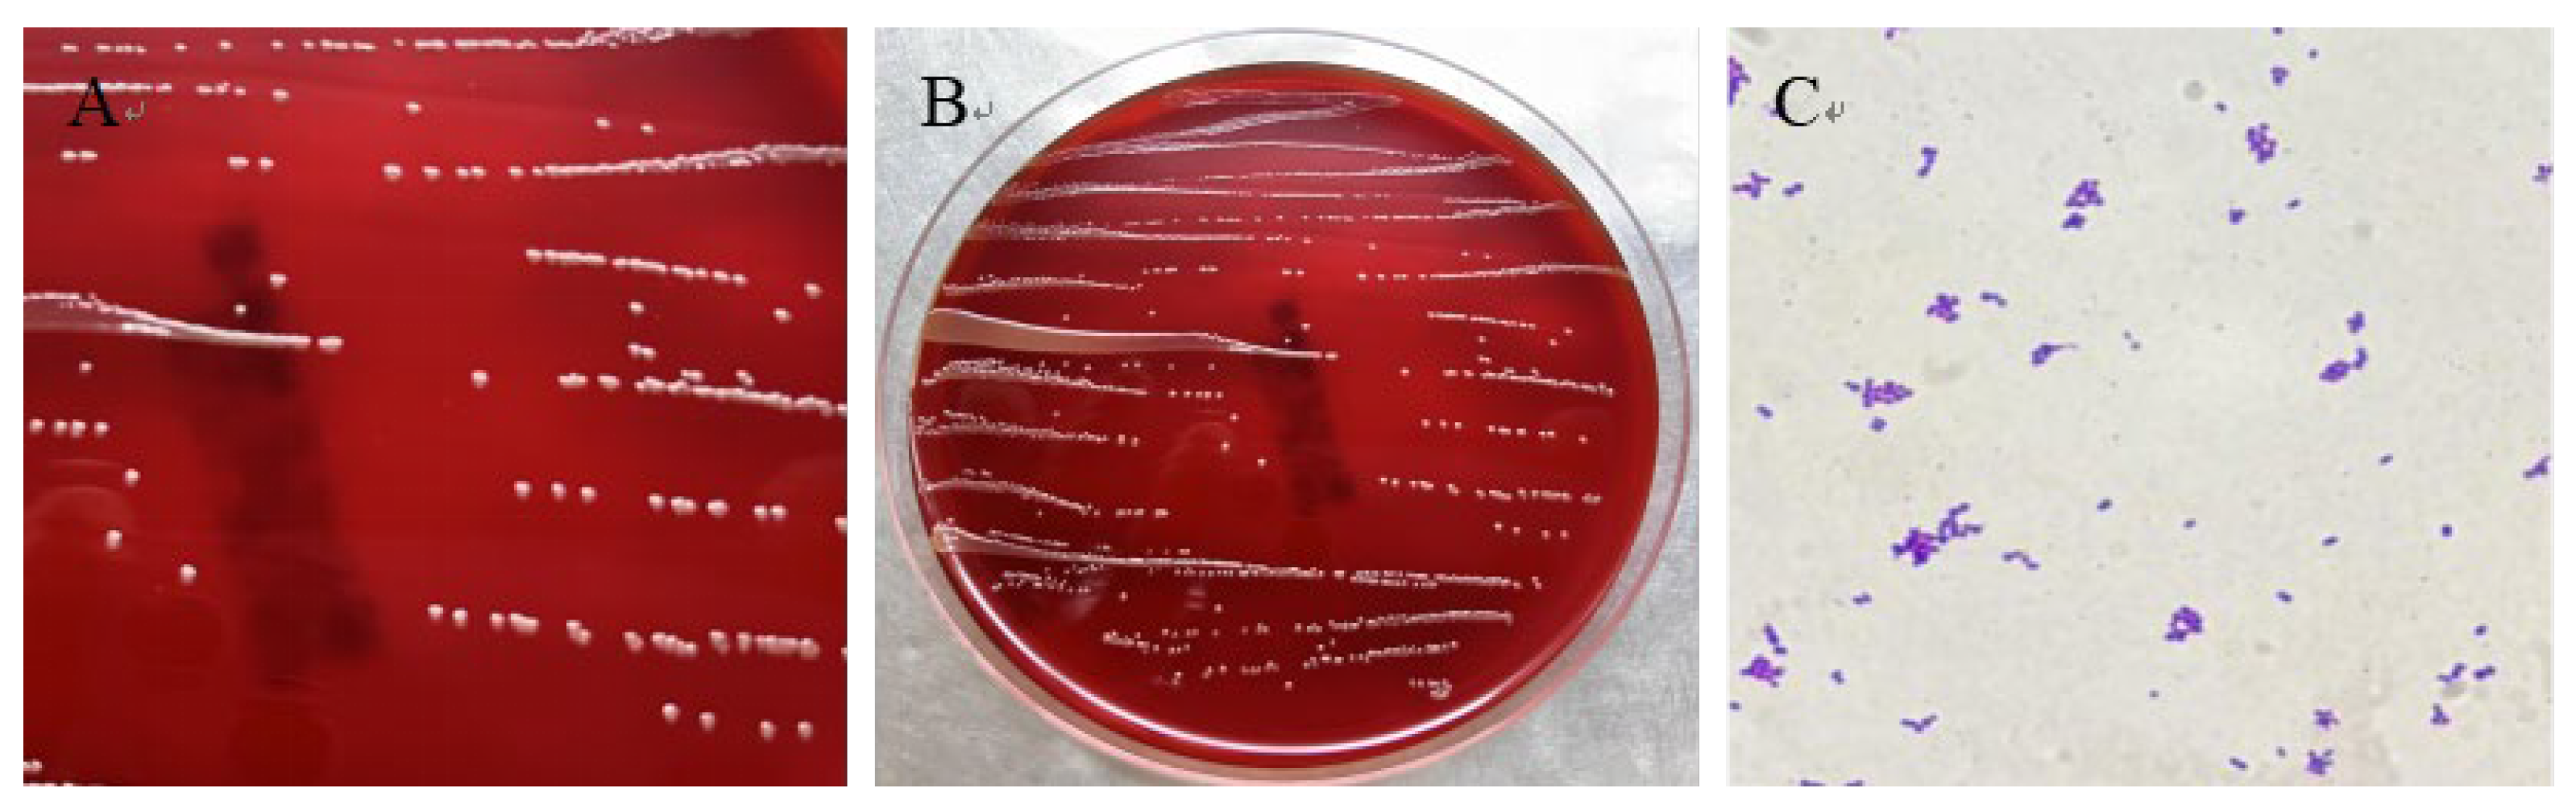
Vetsci 12 00969 g003 Vetsci 12 00969 g003

Isolation, Identification, and Antimicrobial Susceptibility of Exiguobacterium mexicanum from a Giraffe
Abstract
Simple Summary
Abstract
1. Introduction
2. Materials and Methods
2.1. Case Reports and Pathological Examination
2.2. Bacterial Isolation and Morphological Observation
2.3. Molecular Identification
2.4. Antibiotic Susceptibility Testing
3. Results
3.1. Clinical and Pathological Findings in the Deceased Giraffe
3.2. Histopathological Findings in the Deceased Giraffe
3.3. Bacterium Isolation and Microscopic Examination
3.4. Strain HN-1 Was Identified as E. mexicanum
3.5. Antimicrobial Susceptibility Detection
4. Discussion
5. Conclusions
Author Contributions
Funding
Institutional Review Board Statement
Informed Consent Statement
Data Availability Statement
Conflicts of Interest
References
- Bashaw, M.J.; Tarou, L.R.; Maki, T.S.; Maple, T.L. A survey assessment of variables related to stereotypy in captive giraffe and okapi. Appl. Anim. Behav. Sci. 2001, 73, 235–247. [Google Scholar] [CrossRef]
- Kearney, C.C.; Ball, R.L.; Hall, M.B. Effects of altering diet carbohydrate profile and physical form on zoo-housed giraffe Giraffa camelopardalis reticulata. J. Anim. Physiol. Anim. Nutr. 2024, 108, 1119–1133. [Google Scholar] [CrossRef] [PubMed]
- Saito, M.; Matsunaga, M.; Fukuizumi, H.; Nakamichi, M.; Kinoshita, K. Factors affecting captive female giraffe stress response: Male presence, small enclosure, and low temperature. Zoo Biol. 2023, 42, 632–643. [Google Scholar] [CrossRef] [PubMed]
- Passos, L.F.; Garcia, G.; Young, R.J. Comparing the bacterial communities of wild and captive golden mantella frogs: Implications for amphibian conservation. PLoS ONE 2018, 13, e0205652. [Google Scholar] [CrossRef] [PubMed]
- Diaz, J.; Reese, A.T. Possibilities and limits for using the gut microbiome to improve captive animal health. Anim. Microbiome 2021, 3, 89. [Google Scholar] [CrossRef]
- Schmidt, D.A.; Barbiers, R.B.; Ellersieck, M.R.; Ball, R.L.; Koutsos, E.A.; Griffin, M.E.; Grobler, D.; Citino, S.B.; Bush, M. Serum Chemistry Comparisons Between Captive and Free-ranging Giraffes (Giraffa camelopardalis). J. Zoo Wildl. Med. 2011, 42, 33–39. [Google Scholar] [CrossRef]
- Hernández-Reyes, A.L.; Chávez-Gris, G.; Maldonado-Castro, E.; Alcaraz-Sosa, L.E.; Díaz-Negrete, M.T. First identification of Mycobacterium avium subsp. paratuberculosisin wild ruminants in a zoo in Mexico. Vet. World 2022, 15, 655–661. [Google Scholar] [CrossRef]
- Wang, J.; Wang, Y.; Ding, Y.; Suljid, J.; Wang, W. Oral and pulmonary necrobacillosis in a juvenile reticulated giraffe. J. Vet. Diagn. Investig. 2021, 33, 345–347. [Google Scholar] [CrossRef]
- Hlokwe, T.M.; Michel, A.L.; Mitchel, E.; Gcebe, N.; Reininghaus, B. First detection of Mycobacterium bovis infection in Giraffe (Giraffa camelopardalis) in the Greater Kruger National Park Complex: Role and implications. Transbound. Emerg. Dis. 2019, 66, 2264–2270. [Google Scholar] [CrossRef]
- Armstrong, D.P.; Seddon, P.J. Directions in reintroduction biology. Trends Ecol. Evol. 2008, 23, 20–25. [Google Scholar] [CrossRef]
- Chen, X.; Wang, L.; Zhou, J.; Wu, H.; Li, D.; Cui, Y.; Lu, B. Exiguobacterium sp. A1b/GX59 isolated from a patient with community-acquired pneumonia and bacteremia: Genomic characterization and literature review. BMC Infect. Dis. 2017, 17, 508. [Google Scholar] [CrossRef] [PubMed]
- Shen, L.; Liu, Y.; Chen, L.; Lei, T.; Ren, P.; Ji, M.; Song, W.; Lin, H.; Su, W.; Wang, S.; et al. Genomic basis of environmental adaptation in the widespread poly-extremophilic Exiguobacterium group. ISME J. 2024, 18, wrad020. [Google Scholar] [CrossRef] [PubMed]
- López-Cortés, A.; Schumann, P.; Pukall, R.; Stackebrandt, E. Exiguobacterium mexicanum sp. nov. and Exiguobacterium artemiae sp. nov.; isolated from the brine shrimp Artemia franciscana. Syst. Appl. Microbiol. 2006, 29, 183–190. [Google Scholar] [CrossRef] [PubMed]
- Lei, J.; Zheng, M.; Wang, L.; Yin, G.; Lou, Y.; Shi, L. Complete genome sequence of Exiguobacterium mexicanum A-EM, isolated from seafloor hydrothermal vents in Atlantic Ocean. Mar. Genom. 2021, 55, 100801. [Google Scholar] [CrossRef]
- Heidari, R.; Akbariqomi, M.; Tavoosidana, G.; Rigib, G. Exiguobacterium sp. HA2, isolated from the Ilam Mountains of Iran. bioRxiv 2021. [Google Scholar] [CrossRef]
- Remonsellez, F.; Castro-Severyn, J.; Pardo-Esté, C.; Aguilar, P.; Fortt, J.; Salinas, C.; Barahona, S.; León, J.; Fuentes, B.; Areche, C.; et al. Characterization and Salt Response in Recurrent Halotolerant Exiguobacterium sp. SH31 Isolated from Sediments of Salar de Huasco, Chilean Altiplano. Front. Microbiol. 2018, 9, 2228. [Google Scholar] [CrossRef]
- Erofeevskaia, L.A.; Popova, L.L.; Saltycova, A.L. Properties of strain of Exiguobacterium mexicanum. Int. Res. J. IRJ 2016, 53, 46. [Google Scholar] [CrossRef]
- Liu, B.; Sun, Y.; Du, T.; Chen, Y.; Wang, X.; Huan, B.; Li, H.; Nan, Y.; Xiao, S.; Zhang, G.; et al. Rabbit hepatitis E virus is an opportunistic pathogen in specific-pathogen-free rabbits with the capability of cross-species transmission. Vet. Microbiol. 2017, 208, 125–130. [Google Scholar] [CrossRef]
- Yan, Y.; Wang, Y.; Cui, Y.; Wang, J.; Fan, S.; Ning, C. Molecular detection and phylogenetic analysis of Anaplasma phagocytophilum and related strains in cattle from Henan, China. Vet. Sci. 2025, 12, 252. [Google Scholar] [CrossRef]
- Clinical and Laboratory Standards Institute. CLSI M100™ Performance Standards for Antimicrobial Susceptibility Testing, 35th ed.; CLSI: Wayne, PA, USA, 2025; Available online: https://clsi.org/shop/standards/m100/ (accessed on 22 September 2025).
- Robertson, L.J.; Clark, C.G.; Debenham, J.J.; Dubey, J.P.; Kvác, M.; Li, J.; Ponce-Gordo, F.; Ryan, U.; Schares, G.; Su, C.; et al. Are molecular tools clarifying or confusing our understanding of the public health threat from zoonotic enteric protozoa in wildlife? Int. J. Parasitol. Parasites Wildl. 2019, 9, 323–341. [Google Scholar] [CrossRef]
- Li, J.; Karim, M.R.; Siddiki, S.H.M.F.; Chen, Y.; Qin, Z.; Rume, F.I.; Zhang, L. Potential zoonotic transmission of Giardia duodenalis between children and calves in Bangladesh. Transbound. Emerg. Dis. 2023, 2023, 8224587. [Google Scholar] [CrossRef]
- Srivastava, N.; Kumar, S.; Shiburaj, S.; Gupta, A.; Khare, S.K. Cellular adaptation responses in a halotolerant Exiguobacterium exhibiting organic solvent tolerance with simultaneous protease production. Environ. Technol. Innov. 2021, 23, 101803. [Google Scholar] [CrossRef]
- Zhang, D.-C.; Zhu, Z.; Li, X.; Guan, Z.; Zheng, J. Comparative genomics of Exiguobacterium reveals what makes a cosmopolitan bacterium. bioRxiv 2020. [CrossRef] [PubMed]
- Pitt, T.L.; Malnick, H.; Shah, J.; Chattaway, M.A.; Keys, C.J.; Cooke, F.J.; Shah, H.N. Characterisation of Exigobacterium aurantiacum isolates from blood cultures of six patients. Clin. Microbiol. Infect. 2007, 13, 946–948. [Google Scholar] [CrossRef] [PubMed]
- Ed-Dra, A.; Abdallah, E.M.; Sulieman, A.M.E.; Anarghou, H. Harnessing medicinal plant compounds for the control of Campylobacter in foods: A comprehensive review. Vet. Res. Commun. 2024, 48, 2877–2900. [Google Scholar] [CrossRef] [PubMed]
- Stephenson, M.M.; Coleman, M.E.; Azzolina, N.A. Trends in Burdens of Disease by Transmission Source (USA, 2005–2020) and Hazard Identification for Foods: Focus on Milkborne Disease. J. Epidemiol. Glob. Health 2024, 14, 787–816. [Google Scholar] [CrossRef]
- Zhu, N.P.; Ren, H.J.; Yang, L.L.; Mao, G.H.; Li, J.B.; Su, C.L.; Yang, Y.R. Direct evidence of cheetah (Acinonyx jubatus) as intermediate host of Toxoplasma gondii through isolation of viable strains. BMC Vet. Res. 2022, 18, 376. [Google Scholar] [CrossRef]
- Nakov, D.; Hristov, S.; Stankovic, B.; Pol, F.; Dimitrov, I.; Ilieski, V.; Mormede, P.; Hervé, J.; Terenina, E.; Lieubeau, B.; et al. Methodologies for Assessing Disease Tolerance in Pigs. Front. Vet. Sci. 2019, 5, 329. [Google Scholar] [CrossRef]
- Kasana, R.C.; Pandey, C.B. Exiguobacterium: An overview of a versatile genus with potential in industry and agriculture. Crit. Rev. Biotechnol. 2017, 38, 141–156. [Google Scholar] [CrossRef]
- Cui, Y.; Cui, Y.-W.; Huang, J.-L. A novel halophilic Exiguobacterium mexicanum strain removes nitrogen from saline wastewater via heterotrophic nitrification and aerobic denitrification. Bioresour. Technol. 2021, 333, 125189. [Google Scholar] [CrossRef]
- Iyer, R.; Damania, A. Draft Genome Sequence of Exiguobacterium sp. KKBO11, Isolated Downstream of a Wastewater Treatment Plant in Houston, Texas. Genome Announc. 2016, 4, 10–1128. [Google Scholar] [CrossRef]
- Cui, X.D.; Zhang, J.K.; Sun, Y.W.; Yan, F.B.; Zhao, J.F.; He, D.D.; Pan, Y.S.; Yuan, L.; Zhai, Y.J.; Hu, G.Z. Synergistic antibacterial activity of baicalin and EDTA in combination with colistin against colistin-resistant Salmonella. Poult. Sci. 2025, 104, 102094. [Google Scholar] [CrossRef]
- Yuan, X.; Lv, Z.; Zhang, Z.; Han, Y.; Liu, Z.; Zhang, H. A Review of Antibiotics, Antibiotic Resistant Bacteria, and Resistance Genes in Aquaculture: Occurrence, Contamination, and Transmission. Toxics 2023, 11, 420. [Google Scholar] [CrossRef] [PubMed]
- Liu, J.; Hao, D.; Ding, X.; Shi, M.; Wang, Q.; He, H.; Cheng, B.; Wang, M.; Wang, Q.; Xiang, Y.; et al. Epidemiological investigation and β-lactam antibiotic resistance of Riemerella anatipestifer isolates with waterfowl origination in Anhui Province, China. Poult. Sci. 2025, 104, 102041. [Google Scholar] [CrossRef] [PubMed]
- Bai, Y.; Wang, Q.; Liu, M.; Bian, L.; Liu, J.; Gao, F.; Mao, Q.; Wang, Z.; Wu, X.; Xu, M.; et al. The next major emergent infectious disease: Reflections on vaccine emergency development strategies. Expert Rev. Vaccines 2022, 21, 471–481. [Google Scholar] [CrossRef] [PubMed]
- Levings, R.L. Emerging and exotic zoonotic disease preparedness and response in the United States—Coordination of the animal health component. Zoonoses Public Health 2012, 59 (Suppl. S2), 80–94. [Google Scholar] [CrossRef]
- Cohn, J.; Mendelson, M.; Kanj, S.S.; Shafiq, N.; Boszczowski, I.; Laxminarayan, R. Accelerating antibiotic access and stewardship: A new model to safeguard public health. Lancet. Infect. Dis. 2024, 24, e584–e590. [Google Scholar] [CrossRef]

| Antibiotics | Medication Dose (ug/disk) | IZD (mm) | Sensitivity | Judgment Standard of Inhibition Zone Diameter (mm) | ||
|---|---|---|---|---|---|---|
| Resistant | Intermediate | Sensitive | ||||
| Gentamicin | 10 | 21.1 | S | ≤12 | 13~14 | ≥15 |
| Ciprofloxacin | 5 | 12.4 | R | ≤15 | 16~20 | ≥21 |
| Chloramphenicol | 30 | 24 | S | ≤12 | 13~17 | ≥18 |
| Erythromycin | 15 | 20.5 | I | ≤13 | 14~22 | ≥23 |
| Doxycycline | 30 | 21 | S | ≤12 | 13~15 | ≥16 |
| Levofloxacin | 5 | 20 | S | ≤15 | 16~18 | ≥19 |
| Tetracycline | 30 | 26 | S | ≤14 | 15~18 | ≥19 |
| Minocycline | 30 | 27 | S | ≤14 | 15~18 | ≥19 |
| Trimethoprim | 5 | 10.5 | I | ≤10 | 11~15 | ≥16 |
| Clindamycin | 2 | 22 | S | ≤14 | 15~20 | ≥21 |
| Linezolid | 30 | 15.2 | R | ≤22 | 23~25 | ≥26 |
| Rifampicin | 5 | 17 | I | ≤16 | 17~19 | ≥20 |
| Oxacillin | 1 | 9.7 | R | ≤24 | — | ≥25 |
| Penicillin | 10 | 16.6 | R | ≤28 | — | ≥29 |
Disclaimer/Publisher’s Note: The statements, opinions and data contained in all publications are solely those of the individual author(s) and contributor(s) and not of MDPI and/or the editor(s). MDPI and/or the editor(s) disclaim responsibility for any injury to people or property resulting from any ideas, methods, instructions or products referred to in the content. |
© 2025 by the authors. Licensee MDPI, Basel, Switzerland. This article is an open access article distributed under the terms and conditions of the Creative Commons Attribution (CC BY) license (https://creativecommons.org/licenses/by/4.0/).
Share and Cite
Gao, F.; Liang, Q.; Zong, R.; Xie, Y.; Zhao, C.; Yang, Y.; Yu, L.; Li, D.; Duan, H.; Du, W.; et al. Isolation, Identification, and Antimicrobial Susceptibility of Exiguobacterium mexicanum from a Giraffe. Vet. Sci. 2025, 12, 969. https://doi.org/10.3390/vetsci12100969
Gao F, Liang Q, Zong R, Xie Y, Zhao C, Yang Y, Yu L, Li D, Duan H, Du W, et al. Isolation, Identification, and Antimicrobial Susceptibility of Exiguobacterium mexicanum from a Giraffe. Veterinary Sciences. 2025; 12(10):969. https://doi.org/10.3390/vetsci12100969
Chicago/Turabian StyleGao, Fei, Qunchao Liang, Rui Zong, Yuqing Xie, Chenxu Zhao, Yurong Yang, Linyang Yu, Dongliang Li, Hong Duan, Wenjuan Du, and et al. 2025. "Isolation, Identification, and Antimicrobial Susceptibility of Exiguobacterium mexicanum from a Giraffe" Veterinary Sciences 12, no. 10: 969. https://doi.org/10.3390/vetsci12100969
APA StyleGao, F., Liang, Q., Zong, R., Xie, Y., Zhao, C., Yang, Y., Yu, L., Li, D., Duan, H., Du, W., & Li, Y. (2025). Isolation, Identification, and Antimicrobial Susceptibility of Exiguobacterium mexicanum from a Giraffe. Veterinary Sciences, 12(10), 969. https://doi.org/10.3390/vetsci12100969

